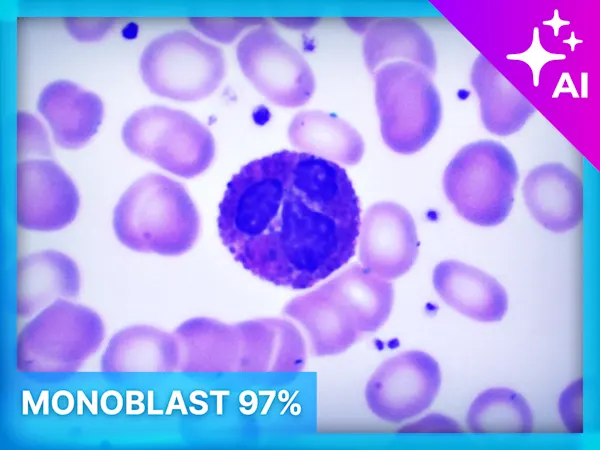

Classification licenses provide vTools for powerful, customizable, deep learning classification algorithms of live images.
Create classification models by annotating images from files. The free choice of deep learning algorithm in, for example, standard ONNX format enables an efficient training process customized to your requirements. Within the pylon AI Platform, you can optimize classification models based on your performance needs and deploy the trained bundle to the pylon Software Suite.
The images can be used for further processing steps based on the classification prediction.